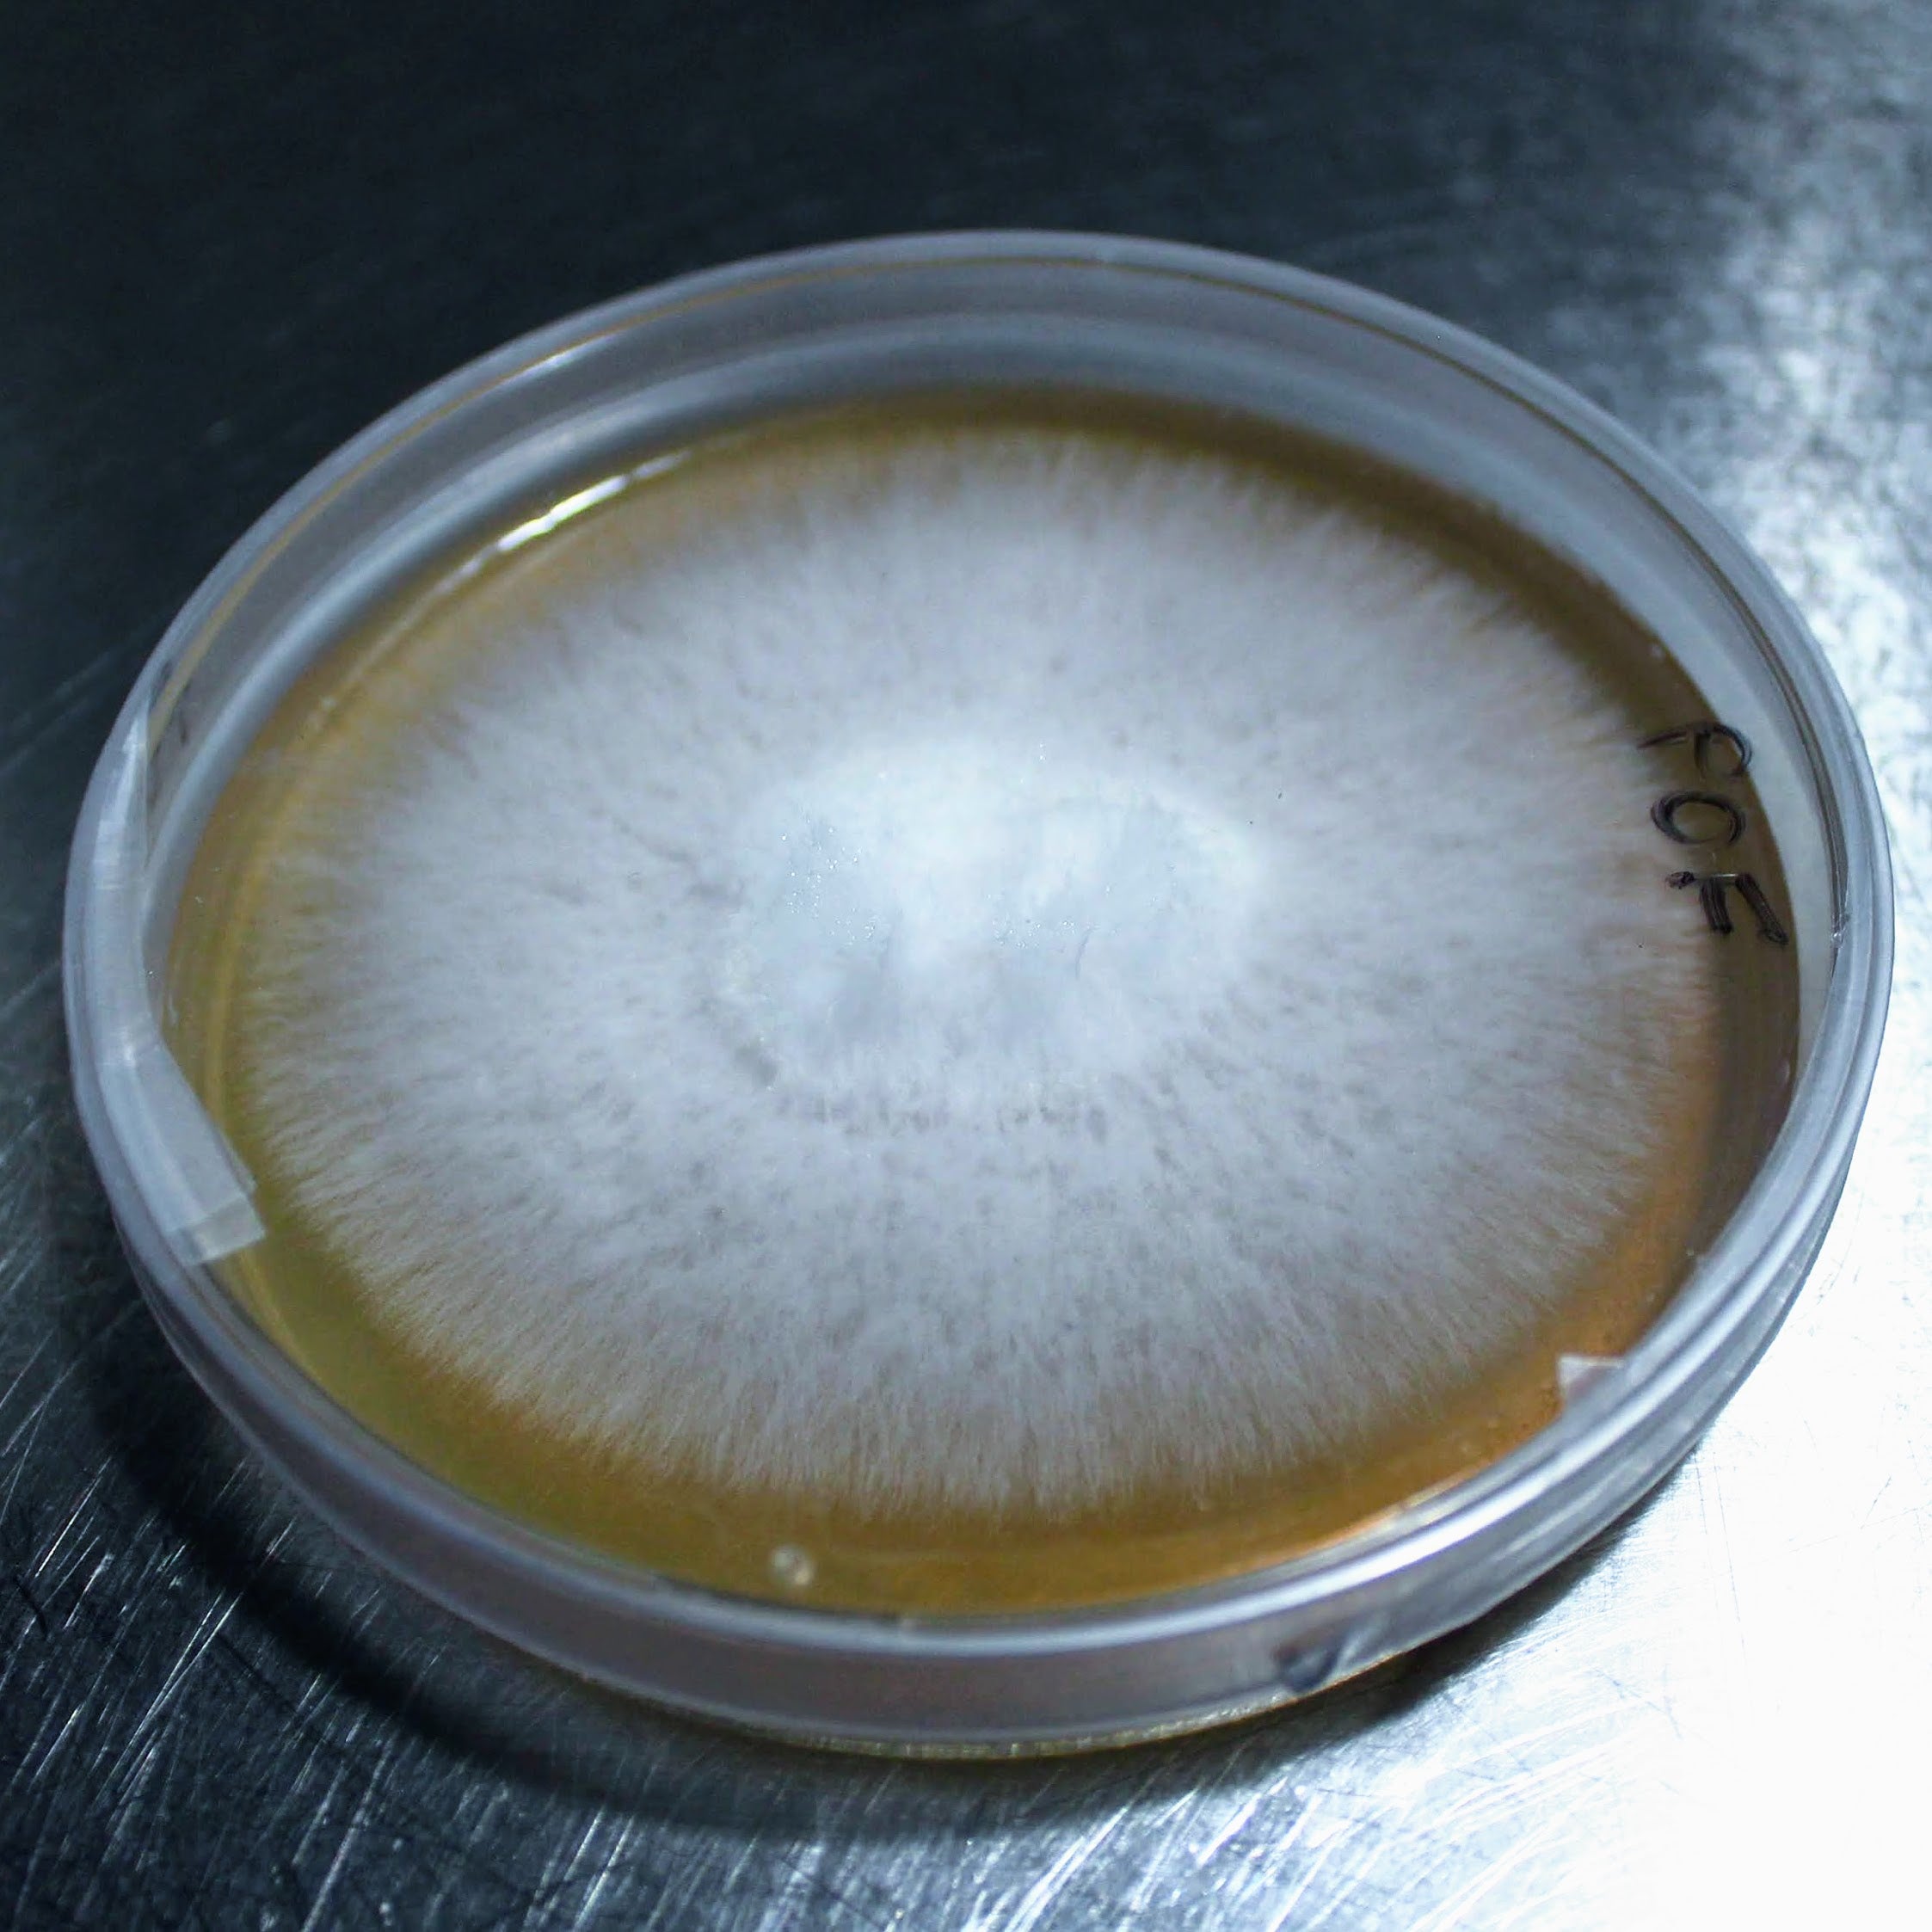
Antibiotischer Malzextrakt-Agar - Nährboden in Petrischalen - 90x14 (mm) - 5 Stück

Pilze – Genetik – Erfolg
MycoGenetics Pilz-Shop - Ihr Partner für professionelle Mykologie & Ertragssicherheit
Seit 2013 ist MycoGenetics spezialisierter Anbieter für hochwertige Pilzbrut und Premium-Substrate. Wir verbinden laborgeprüfte Qualität mit regionalen Rohstoffen, um Zuchtbetrieben und ambitionierten Züchtern maximale Sicherheit zu bieten. Ob Aufbauphase oder kontinuierliche Produktion – wir liefern die Basis für Ihren Erfolg.
🧬Maximierte Bioeffizienz
Unsere selektierten Hochleistungsstämme ("Commercial Strains") stehen für aggressives Wachstum und verkürzte Besiedelungszeiten. Das bedeutet für Sie: Schnellere Zyklen und höhere Ernteerträge pro Substratblock.
🥼 Minimiertes Ausfallrisiko
Durch strenge Steriltechnik und professionelle Laborstandards reduzieren wir das Kontaminationsrisiko auf ein Minimum. Unsere Brut und Substrate bieten Ihnen höchste Reinheit für eine planbare, sichere Produktion ohne böse Überraschungen.
🚀 Verlässliche Skalierbarkeit
Wir nutzen standardisierte, regionale Rohstoffe für eine konstante Substratqualität – Charge für Charge. Ideal für Betriebe, die auf just-in-time Belieferung und gleichbleibende Ergebnisse angewiesen sind.
Mycelspritzen - Liquid cultures
Mycelspritze Igel-Stachelbart (Hericium erinaceus) - 10 ml
Mycelspritze Blauer Austernseitling (Pl. ostreatus var. columbinus)
Mycelspritze Austernseitling (Pleurotus ostreatus) - 10 ml
Mycelspritze Leuchtpilze (Panellus stipticus) - 10 ml
Mycelspritze Puppen-Kernkeule (Cordyceps militaris) - 10 ml
Mycelspritze Rosenseitling (Pleurotus djamor) - 10 ml
Mycelspritze Kräuterseitling (Pleurotus eryngii) - 10 ml
Mycelspritze Shiitake (Lentinula edodes) - 10 ml
Mycelspritze Limonenseitling (Pleurotus citrinopileatus) - 10 ml
Mycelspritze Reishi (Ganoderma lucidum) - 10 ml
Mycelspritze Pioppino (Agrocybe aegerita) - 10 ml
Mycelspritze Chestnut mushroom (Pholiota adiposa) - 10 ml
Unsere Pilzbrut Sorten
Pilzbrut Austernseitling (Pleurotus ostreatus) - 2 Liter
Pilzbrut Rosenseitling (Pleurotus djamor) - 2 Liter
Pilzbrut Kräuterseitling (Pleurotus eryngii) - 2 Liter
Pilzbrut Limonenseitling (Pleurotus citrinopileatus) - 2 Liter
Pilzbrut Shiitake (Lentinula edodes) - 2 Liter Körnerbrut
Pilzbrut Lungenseitling (Pleurotus pulmonarius) - 2 Liter
Pilzbrut Austernseitling Florida - 2 Liter




Pilzbrut Austernseitling (Pleurotus ostreatus) - 2 Liter
Entdecken Sie die Freude an der Pilzzucht mit unserer Pilzbrut Austernseitling (Pleurotus ostreatus) im 2-Liter-Mikrofilterbeutel! Unser spezieller Stamm MG1005 macht die Kultivierung einfacher und effizienter. Er ist bekannt für seine außergewöhnliche Ertragsstärke und Anpassungsfähigkeit. Ein besonderes Highlight: Als sporenfreier Stamm ist MG1005 ideal für die Indoorpilzzucht und bietet maximalen Komfort.
Lieferzeit aktuell ca. 10 Werktage
Beliebteste Artikel
Pilzbrut Austernseitling (Pleurotus ostreatus) - 2 Liter
Mycelspritze Igel-Stachelbart (Hericium erinaceus) - 10 ml
PF-Tek Substrat (Original) - 1 Liter Reismehl & Vermiculit
Mycelspritze Blauer Austernseitling (Pl. ostreatus var. columbinus)
Pilzbrut Rosenseitling (Pleurotus djamor) - 2 Liter
4x Mycotainer 1200 ml - PF-Tek Dose